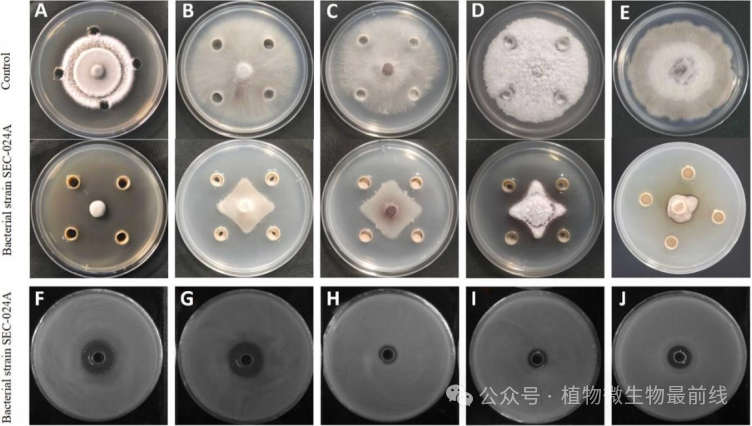
图片
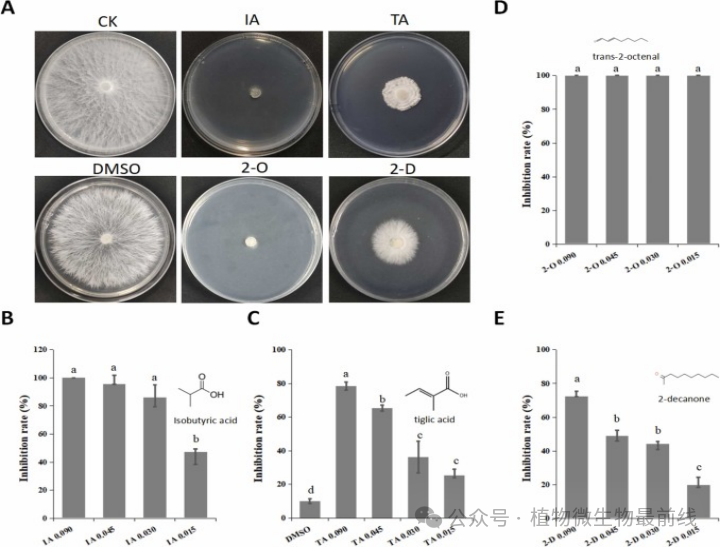
图片

特色经济作物因为独特的作物特性和经济价值在农业领域扮演着重要角色。随着微生物组学相关技术的不断应用,其内生、根际、叶围等微生物资源也逐步展现其独特优势,在作物促生长、生物修复、抑菌物质发掘利用方面具有巨大开发价值和潜力。
工业大麻(Cannabis sativaL.)在我国被称为汉麻,在生物医药、食品添加、纺织纤维、复合材料、生活用品等多个领域均匀广泛应用。我国是工业大麻种植面积最大的国家,占全世界的一半左右。为充分发掘这一生物资源,近日,中国农业科学院麻类研究所特色作物绿色低碳生产技术创新团队在《Industrial Crops & Products》(农林科学一区,IF:5.6)上发表了题为“Biocontrol potential of Bacillus velezensis SEC-024A against southern blight of industrial hemp”的研究论文。该团队对工业大麻内生微生物资源进行规模挖掘,以齐整小核菌(Agroathelia rolfsii)引起的顽固性土传病害大麻白绢病病原为主要靶标对象,并从工业大麻植株中成功分离出一株广谱、高效的内生贝莱斯芽孢杆菌SEC-024A,并结合相关组学技术进行了抑菌机制解析与活性物质的挖掘。

该研究团队首先从工业大麻叶内分离出多株对大麻白绢病菌效果良好的生防菌株,其中SEC-024A抑菌效果最为显著,平板抑菌率高达80.5%,在盆栽实验中对大麻白绢病的控制效果达74.1%。抗菌谱试验显示该菌株对多种病原真菌、卵菌和细菌均具有拮抗作用,其中对稻瘟病菌( Magnaporthe oryzae)的抑制率最高为98.97%。研究人员进一步通过16S rDNA测序、生理生化测定和全基因组测序,将其鉴定为贝莱斯芽孢杆菌(Bacillus velezensis)。通过对SEC-024A 的全基因组测序和基因功能注释分析发现,该菌株拥有与次生代谢物合成相关的多个基因簇,还含有与植物生长、生物防治和定殖相关的基因,极具生防菌剂开发潜力。

图1.SEC-024A菌株对大麻白绢病菌的防控效果
图2.SEC-024A菌株对多种植物病原菌的拮抗作用为探寻有效抑菌成分,该研究进一步采用双皿对扣法进行试验。结果表明,SEC-024A菌株所产的挥发性有机物(VOCs)在抑菌拮抗过程中发挥着关键作用。研究人员结合GC-MS检测和双皿对扣技术,从SEC-024A的VOCs 中成功筛选挖掘出4种对病原菌具有高效抑菌作用的化合物——异丁酸、惕格酸、反式-2-辛烯醛和 2-癸酮,其对大麻白绢病菌的EC50值分别为 0.012、0.038、0.009 和 0.046 μL/mL。其中反式-2-辛烯醛对多种经济作物的土传病害病原显示出广谱抑菌活性。
图 3. SEC-024A产生的挥发性有机物对A. rolfsii 的抑菌作用。

图 4. SEC-024A产生的挥发性有机物对多种土传病原菌的生长抑制作用。综上所述,本研究从大麻叶中分离、筛选和鉴定出了一株新的具有广谱抑菌活性的贝莱斯芽孢杆菌SEC-024A,并揭示了其关键抑菌化合物。研究结果不仅为SEC - 024A在生产实际中的应用奠定了基础,也凸显了VOCs在SEC - 024A生防机制中的重要意义。中国农业科学院麻类研究所/南方经济作物中心王吐虹副研究员、硕士研究生李文婷为论文的共同第一作者,程毅副研究员、邱化蛟研究员和麦克马斯特大学徐建平教授为论文共同通讯作者。该研究得到了中国农业科学院创新工程、中医药农业生物基因组学湖南省重点实验室等项目的资助。Biocontrol potential of Bacillus velezensis SEC-024A against southern blight of industrial